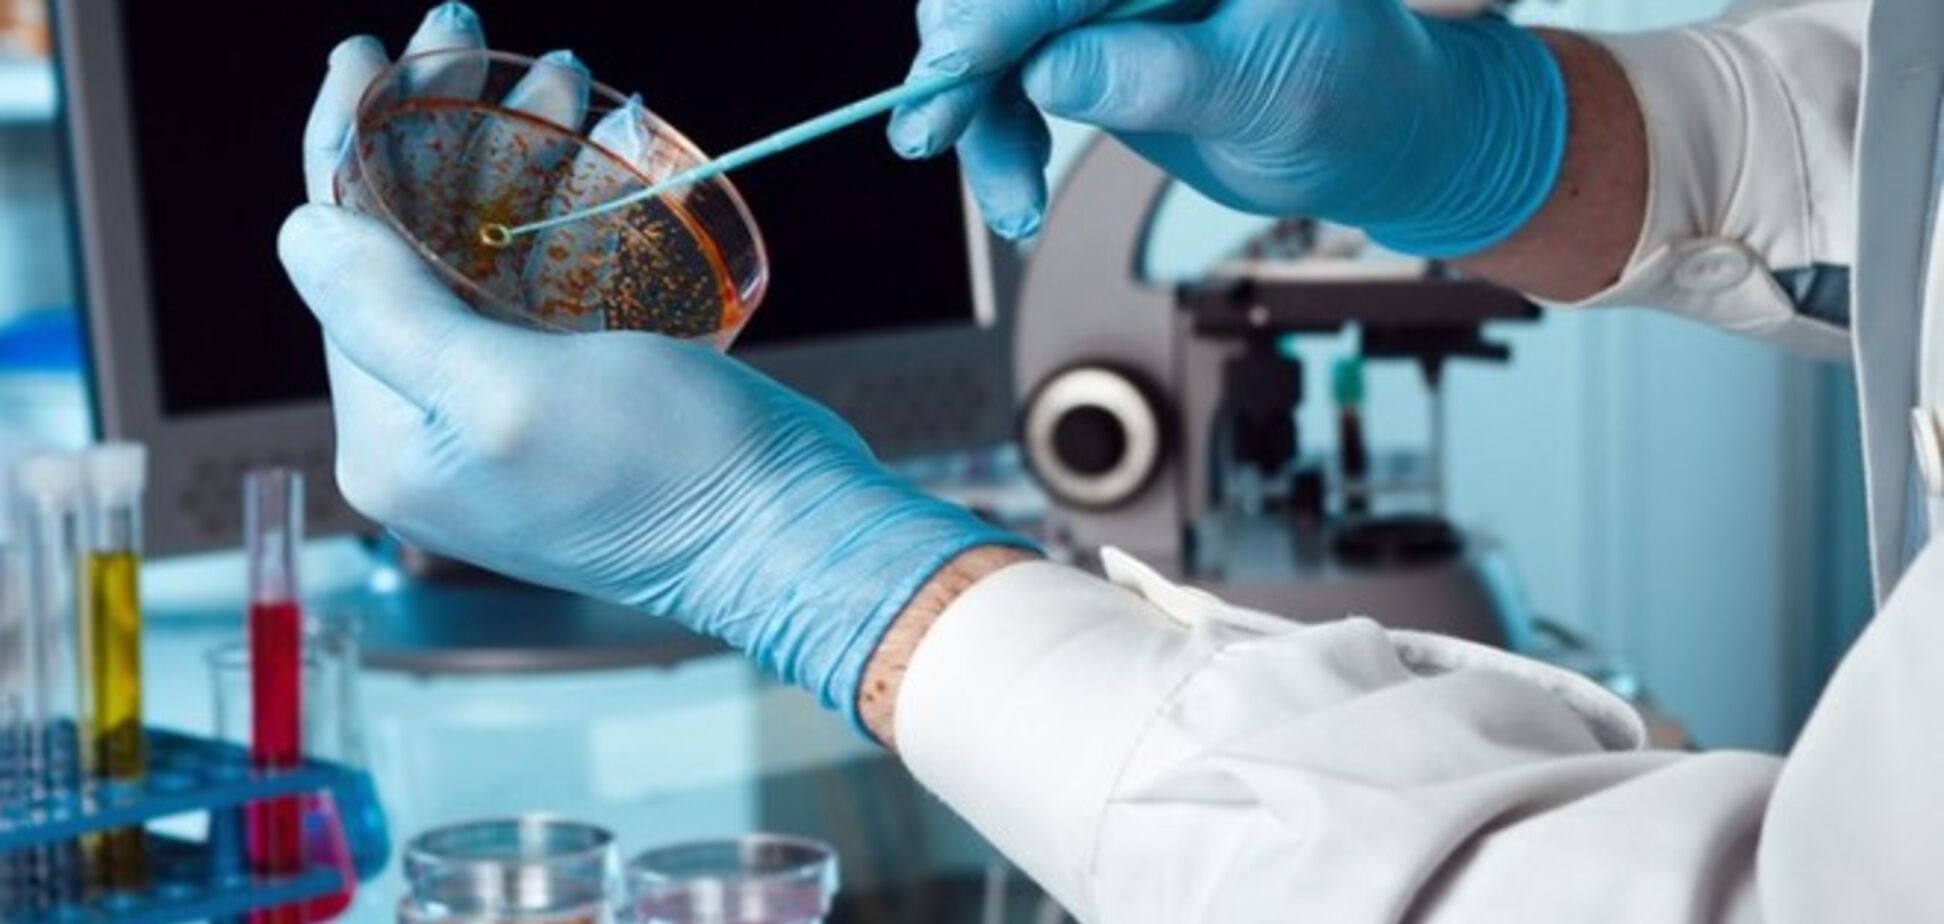
Ученые нашли быстрый способ обнаружить вирус Эбола

Ebolavirus (также известен как вирус Эбола и эболавирус) – род вирусов семейства филовирусов, которые вызывают геморрагическую лихорадку Эбола.
Первым из рода был обнаружен вирус Zaire ebolavirus. Он был выделен в 1976 году в бассейне реки Эбола в Заире, за что и получил свое название.
Виды эболавирусов
Род Ebolavirus делится на шесть видов, четыре из которых опасны для человека. Патогенность еще одного вида для человека пока не доказана.
Zaire ebolavirus
Зафиксирован в 1976 году. Это самый частый вид эболавируса. Его летальность достигает 90%, а средний коэффициент смертности – 83%.
Sudan ebolavirus
Зафиксирован примерно в то же время, что и Zaire ebolavirus. Первая вспышка возникла на фабрике в городе Нзара в Судане. Последняя вспышка – ноябрь 2012 – январь 2013 года.
Максимальный уровень летальности был зафиксирован в 1979 году и составил 68%.
Reston ebolavirus
Впервые был обнаружен на Филиппинах в 1989 году во время вспышки вируса геморрагической лихорадки обезьян. Источником оказались макаки-крабоеды, которые были увезены в одну из исследовательских лабораторий в Рестоне, США. Вспышка болезни была зафиксирована на Филиппинах, в Италии и США.
Не является патогенным для человека, но поражает обезьян и свиней.
Taï Forest ebolavirus
Впервые обнаружен в 1994 году у шимпанзе в лесу Таи в Кот-д’Ивуаре. Болезнь подхватила также одна из ученых, проводивших вскрытие погибшего животного. Она выздоровела спустя шесть недель лечения в Швейцарии.
Bundibugyo ebolavirus
Обнаружен в 2007 году в районе Бундибугио в Уганде. Вспышка продолжалась с конца ноября 2007 года до конца февраля 2008 года. 37 из 149 заболевших умерли. В последний раз Bundibugyo ebolavirus был зафиксирован в 2012 году в Конго. Его летальность составила 36%.
Bombali ebolavirus
Обнаружен в 2018 году в округе Бомбали на севере Сьерра-Леоне. Вирус был выявлен у двух видов насекомоядных летучих мышей — ангольского складчатогуба Mops condylurus и малого складчатогуба Chaerephon pumilus. Позже также был обнаружен у складчатогубов Mops condylurus в Кении и Гвинее.
Лабораторные эксперименты показали, что вирус способен заражать клетки человека in vitro (в пробирке), однако подтвержденных случаев обнаружения вируса у человека нет.
Как передается вирус Эбола
Способы передачи эболавируса:
через телесные жидкости;
при употреблении мяса зараженного животного (в случае плохой термальной обработки);
при попадании капель крови зараженного животного в глаза, нос и другие слизистые;
через фрукты, которые ели инфицированные животные;
через кровь, другие жидкости и ткани от инфицированного человека к здоровому;
возможна передача через контакт слизистых оболочек с одеждой, постельным бельем инфицированного.
При этому вирус не передается воздушно-капельным путем.
Инкубационный период для эболавируса составляет от 2 до 21 дня. Пока у инфицированного не проявились первые симптомы заболевания, он остается незаразным.
Геморрагическая лихорадка Эбола
Эболавирус провоцирует опасную лихорадку Эбола. Ее сиптомы:
резкое повышение температуры тела;
общая слабость;
мышечные и головные боли;
боли в горле.
У заболевшего могут наблюдаться:
рвота;
диарея (иногда с кровью);
нарушение функций почек и печени;
сыпь.
В некоторых случаях также возможны внутренние и внешние кровотечения.
Тесты в лабораториях фиксируют у заболевших низкие уровни белых кровяных клеток и тромбоцитов. Вместе с тем фиксируется повышенное содержание ферментов печени.
Лечение геморрагической лихорадки Эбола
Необходима обязательная госпитализация и изоляция в специально оборудованных боксах. К больным лихорадкой Эбола допускается только специально обученный персонал. В ходе терапии применяются противовирусные препараты, больному вводят донорские иммуноглобулины.
Больному необходим постельный режим, полужидкая легкоусвояемая пища, при сильном обезвоживании, назначается прием солевых растворов или раствора глюкозы, витаминотерапия.
В некоторых случаях проводится гемодиализ, назначаются жаропонижающие препараты и антибиотики, в случае развития бактериальных осложнений. В ходе вспомогательной терапии, больному назначаются такие препараты как: Аскорутин, Витамин В6, Регидрон.
Эпидемии Эболы
Во время вспышки болезни в 2014-2016 годах в Гвинее, Либерии и Сьерра-Леоне Эболой заразились около 28 тысяч человек, более 11 тысяч из них умерли.
Одна из крупнейших вспышек заболевания произошла в 2015 году, когда эболавирус выявили у более 30 тысяч человек, из которых умерли почти 13 тысяч.
Летом 2020 года было объявлено о победе над вспышкой болезни в Конго, которая продолжалась почти два года и унесла жизни более 2 тысяч человек.
В феврале 2021 года Гвинея объявили о новой эпидемии лихорадки Эбола.
Вакцина против Эболы
Клинические испытания вакцины против вируса Эбола были проведены в 2016 году. Вакцина была разработана учеными из Канады и показала высокую эффективность.